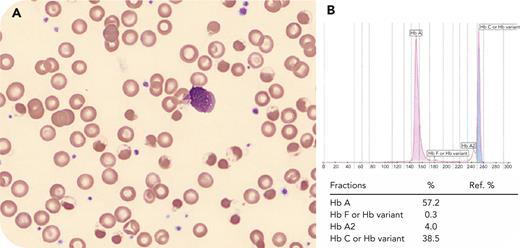
graphic

A previously healthy 7-year-old African American boy was admitted for anemia and hemoglobinuria. He appeared well, with reassuring vitals and physical examination. Complete blood count showed normocytic anemia (hemoglobin [Hb] 5.7 g/dL, mean corpuscular volume 82.5 fL), leukocytosis (white blood cell count 14.79 × 109/L), normal reticulocyte count (0.078 × 109/L), normal platelet count (243 × 109/L), and no blasts. Other laboratory values included increased indirect bilirubin (3.1 mg/dL), lactate dehydrogenase (2633 U/L), and normal creatinine and uric acid. A urine dip showed 3+ blood with no red blood cells. Renal ultrasound was normal. The peripheral blood smear demonstrated many eccentrocytes, pyknocytes, and some target cells (panel A, Wright’s stain, original magnification ×1000). Hb electrophoresis was consistent with Hb C trait (panel B), which was confirmed by high-performance liquid chromatography. Osmotic fragility test was normal. Glucose-6-phosphate dehydrogenase (G6PD) enzyme activity was low (2.6 U/g Hb). The patient was subsequently diagnosed with hemolytic anemia due to G6PD deficiency.
The coexistence of Hb C trait and G6PD deficiency is rare, and the combination leads to an increased risk of hemoglobin precipitation and hemolytic anemia. This is especially true when exposed to known triggers, such as fava beans, infections, and certain medications, since both conditions can make red blood cells vulnerable to oxidative damage. This damage can lead to hemolysis and formation of eccentrocytes and pyknocytes as seen in our patient.
For additional images, visit the ASH Image Bank, a reference and teaching tool that is continually updated with new atlas and case study images. For more information, visit https://imagebank.hematology.org.

This feature is available to Subscribers Only
Sign In or Create an Account Close Modal